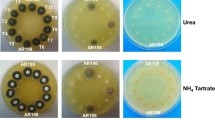

Abstract
The catabolism of d-galactose in yeast depends on the enzymes of the Leloir pathway. In contrast, Aspergillus nidulans mutants in galactokinase (galE) can still grow on d-galactose in the presence of ammonium—but not nitrate—ions as nitrogen source. A. nidulans galE mutants transiently accumulate high (400 mM) intracellular concentrations of galactitol, indicating that the alternative d-galactose degrading pathway may proceed via this intermediate. The enzyme degrading galactitol was identified as l-arabitol dehydrogenase, because an A. nidulans loss-of-function mutant in this enzyme (araA1) did not show NAD+-dependent galactitol dehydrogenase activity, still accumulated galactitol but was unable to catabolize it thereafter, and a double galE/araA1 mutant was unable to grow on d-galactose or galactitol. The product of galactitol oxidation was identified as l-sorbose, which is a substrate for hexokinase, as evidenced by a loss of l-sorbose phosphorylating activity in an A. nidulans hexokinase (frA1) mutant. l-Sorbose catabolism involves a hexokinase step, indicated by the inability of the frA1 mutant to grow on galactitol or l-sorbose, and by the fact that a galE/frA1 double mutant of A. nidulans was unable to grow on d-galactose. The results therefore provide evidence for an alternative pathway of d-galactose catabolism in A. nidulans that involves reduction of the d-galactose to galactitol and NAD+-dependent oxidation of galactitol by l-arabitol dehydrogenase to l-sorbose.









Similar content being viewed by others
References
Ai Y, Zheng Z, O’Brien-Jenkins A, Bernard DJ, Wynshaw-Boris T, Ning C, Reynolds R, Segal S, Huang K, Stambolian D (2000) A mouse model of galactose-induced cataracts. Hum Mol Genet 9:1821–1827
Arst HN, Penalva MA (2003) pH regulation in Aspergillus and parallels with higher eukaryotic regulatory systems. Trends Genet 19:224–231
Banditelli S, Boldrini E, Vilardo PG, Cecconi I, Cappiello M, Dal Monte M, Marini I, Del Corso A, Mura U (1999) A new approach against sugar cataract through aldose reductase inhibitors. Exp Eye Res 69:533–538
Bettenbrock K, Alpert CA (1998) The gal genes for the Leloir pathway of Lactobacillus casei 64H. Appl Environ Microbiol 64:2013–2019
Bhushan B, Halasz A, Spain J, Thiboutot S, Ampleman G, Hawari J (2002) Biotransformation of hexahydro-1,3,5-trinitro-1,3,5-tiazine catalyzed by a NAD(P)H:nitrate oxidoreductase from Aspergillus niger. Environ Sci Technol 36:3104–3108
Chassy BM, Thompson J (1983) Regulation and characterization of the galactose-phosphoenolpyruvate-dependent phosphotransferase system in Lactobacillus casei. J Bacteriol 154:1204–1214
Chiang C, Knight SG (1959) d-Xylose metabolism by cell-free extracts of Penicillium chrysogenum. Biochim Biophys Acta 35:454–463
Chiang C, Knight SG (1961) l-arabinose metabolism by cell-free extracts of Penicillium chrysogenum. Biochim Biophys Acta 46:271–278
Clutterbuck AJ (1981) An arabinose non-utilizing mutant araA1. Asp Newslett 15:21
Clutterbuck AJ (1997) The validity of the Aspergillus nidulans linkage map. Fungal Genet Biol 21:267–277
De Vries RP, Flipphi JA, Witteveen CFB, Visser J (1994) Characterization of an Aspergillus nidulans l-arabitol dehydrogenase mutant. FEMS Microbiol Lett 123:83–90
Dickson RC, Riley MI (1989) The lactose-galactose regulon of Kluyveromyces lactis. Bio/Technol 13:19–40
Elshafei AM, Abdel-Fatah OM (2001) Evidence for a non-phosphorylated route of galactose breakdown in cell-free extracts of Aspergillus niger. Enzyme Microb Technol 29:76–83
Elorza MV, Arst HN Jr. (1971) Sorbose resistant mutants of Aspergillus nidulans. Mol Gen Genet 111:185–193
Fantes PA, Roberts CF (1973) β-galactosidase activity and lactose utilization in Aspergillus nidulans. J Gen Microbiol 77: 471-486
Fekete E, Karaffa L, Sándor E, Seiboth B, Biró S, Szentirmai A, Kubicek CP (2002) Regulation of formation of the intracellular β-galactosidase activity of Aspergillus nidulans. Arch Microbiol 179:7-14
Felenbok B, Flipphi M, Nikolaev I (2001) Ethanol catabolism in Aspergillus nidulans: a model system for studying gene regulation. Prog Nucleic Acid Res Mol Biol 69:149–204
Frey PA (1996) The Leloir pathway: a mechanistic imperative for three enzymes to change the stereochemical configuration of a single carbon in galactose. FASEB J 10:461–470
Gross KC, Pharr DM (1982) A potential pathway for galactose metabolism in Cucumis sativus L., a stachyose transporting species. Plant Physiol 69:117–121
Hasper AA, Visser J, de Graaff LH (2000) The Aspergillus niger transcriptional activator XlnR, which is involved in the degradation of the polysaccharides xylan and cellulose, also regulates d-xylose reductase gene expression. Mol Microbiol 36:193–200
Kador PF, Inoue J, Secchi EF, Lizak MJ, Rodriguez L, Mori K, Greentree W, Blessing K, Lackner PA, Sato S (1998) Effect of sorbitol dehydrogenase inhibition on sugar cataract formation in galactose-fed and diabetic rats. Exp Eye Res 67:203–208
Käfer E (1977) Meiotic and mitotic recombination in Aspergillus and its chromosomal abberations. Adv Genet 19:33–131
Machado de Domenech EE and Sols A (1980) Specificity of hexokinases towards some uncommon substrates and inhibitors. FEBS Lett 119:174–176
Oesterhelt C, Gross W (2002) Different sugar kinases are involved in the sugar sensing of Galdieria sulphuraria. Plant Physiol 128:291–299
Panneman H, Ruijter GJ, van den Broeck HC, Visser J (1998) Cloning and biochemical characterisation of Aspergillus niger hexokinase—the enzyme is strongly inhibited by physiological concentrations of trehalose 6-phosphate. Eur J Biochem 258:223–232
Peterson GL (1983) Determination of total protein. Methods Enzymol 91:86–105
Pontecorvo G, Roper JA, Hemmons LM, Macdonald KD, Button AWJ (1953) The genetics of Aspergillus nidulans. Adv Genet 5:141–238
Puri RN, Bhatnagar D, Roskoski R Jr. (1988) Inactivation of yeast hexokinase by o-phthalaldehyde: evidence for the presence of a cysteine and a lysine at or near the active site. Biochim Biophys Acta 957:34–46
Raushel FM, Cleland WW (1977) Bovine liver fructokinase: purification and kinetic properties. Biochemistry 16:2169–2175
Roberts CF (1963) The genetic analysis of carbohydrate utilization in Aspergillus nidulans. J Gen Microbiol 31:45–58
Roberts CF (1970) Enzyme lesions in galactose non-utilizing mutants of Aspergillus nidulans. Biochim Biophys Acta 201:267–283
Ruijter GJG, Panneman H, van den Broeck HC, Bennett JM, Visser J (1996) Characterisation of the Aspergillus nidulans frA1 mutant: hexose phosphorylation and apparent lack of involvement of hexokinase in glucose repression. FEMS Microbiol Lett 139:223–228
Shi NQ, Prahl K, Hendrick J, Cruz J, Lu P, Cho JY, Jones S, Jeffries T (2000) Characterization and complementation of a Pichia stipitis mutant unable to grow on d-xylose or l-arabinose. Appl Biochem BioTechnol 84:201–216
Shuster CW, Doudoroff M (1967) Purification of 2-keto-3-deoxy-6-phosphohexonate aldolases of Pseudomonas saccharophila. Arch Mikrobiol 59:279–86
Singh A, Schügerl K (1992) Induction and regulation of d-xylose catabolizing enzymes in Fusarium oxysporum. Biochem Int 28:481–488
Slayman CW, Tatum EL (1964) Potassium transport in Neurospora: I. Intracellular sodium and potassium concentrations, and cation requirements for growth. Biochim Biophys Acta 88:578–592
Van de Werve G, Hers HG (1979) Mechanism of activation of glycogen phosphorylase by fructose in the liver. Stimulation of phosphorylase kinase related to the consumption of adenosine triphosphate. Biochem J 178:119–126
Verduyn C, Van Kleef R, Frank J, Schreuder H, Van Dijken JP, Scheffers WA (1985) Properties of the NAD(P)H-dependent xylose reductase from the xylose-fermenting yeast Pichia stipitis. Biochem J 226:669–677
Witteveen CFB, Busink R, van der Vondervoort P, Dijkema C, Swart K, Visser J (1989) l-arabinose and d-xylose catabolism in Aspergillus niger. J Gen Microbiol 135:2163–2171
Wohrl BM, Sprenger GA, Lengeler JW (1990) Construction of a new catabolic pathway for d-fructose in Escherichia coli K12 using an l-sorbose-specific enzyme from Klebsiella pneumoniae. Arch Microbiol 154:162–167
Yebra MJ, Perez-Martinez G (2002) Cross-talk between the l-sorbose and d-sorbitol (d-glucitol) metabolic pathways in Lactobacillus casei. Microbiol UK 148:2351–2359
Acknowledgements
We are grateful to Professor Axel A. Brakhage (University of Hannover, Germany), Dr. Michel J. A. Flipphi (University of Valencia, Spain) and Dr. George J. Ruijter (Leiden University, The Netherlands) for the A. nidulans R21, frA1 and araA1 strains, respectively. The project was carried out in the framework of an Austrian-Hungarian Intergovernmental Science and Technology Cooperation Programme (A-26/2000, and was grant-aided by the OTKA (Hungarian Scientific Research Fund; grants F 031985 and F 042602) and the FKFP (Fund for Research and Development in Higher Education; grant 0009/2001). Dr. Erzsébet Sándor is a recipient of an OTKA Postdoctoral Fellowship (grant D 37975).
Author information
Authors and Affiliations
Corresponding author
Rights and permissions
About this article
Cite this article
Fekete, E., Karaffa, L., Sándor, E. et al. The alternative d-galactose degrading pathway of Aspergillus nidulans proceeds via l-sorbose. Arch Microbiol 181, 35–44 (2004). https://doi.org/10.1007/s00203-003-0622-8
Received:
Revised:
Accepted:
Published:
Issue Date:
DOI: https://doi.org/10.1007/s00203-003-0622-8